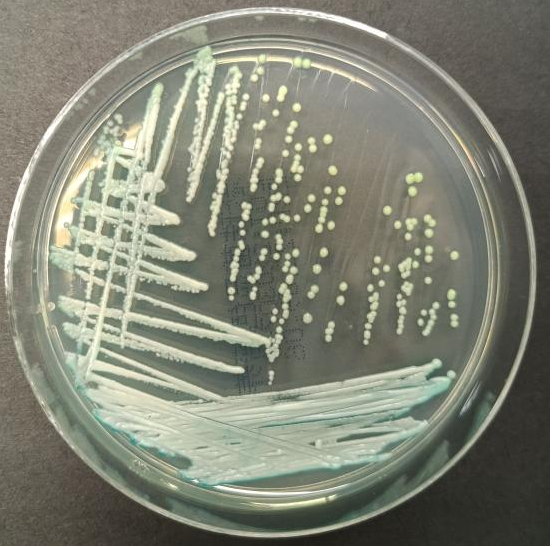
以色列科研人员“复活”80年前真菌标本

以色列科研人员“复活”80年前真菌标本
图片来源于网络,如有侵权,请联系删除
新华社耶路撒冷7月30日电(记者王卓伦 路一凡)以色列耶路撒冷希伯来大学研究人员近日成功“复活”了两株约80年前收集的植物病原真菌样本,为研究现代农业对土壤微生物生态的长期影响提供了重要线索,也为构建更可持续的农业体系提供依据。
这一研究的对象为灰霉菌,是一种全球广泛存在的植物病原真菌,可引发200多种作物的灰霉病,给农业造成高额损失,对全球粮食安全、国际贸易与环境健康构成多重挑战。为寻找工业化农业兴起前土壤微生物群落的原始状态,研究团队从希伯来大学国家自然历史收藏中心选取了两株20世纪40年代采集的灰霉菌标本。这些菌株在合成化肥和杀真菌剂尚未普遍使用的农业体系中自然生长,被科学家视作“化学干预前时代”的微生物样本。
研究人员成功将其“复活”,利用最新技术手段对其进行全基因组测序、转录组分析和代谢组分析,并与当前实验室中广泛使用的现代灰霉菌菌株进行对比。结果发现,老菌株在多个方面表现出与现代菌株的显著差异。比如:老菌株对杀真菌剂的抗性明显更弱;致病能力方面,老菌株在侵入性和寄主特异性上均较低;生态适应性方面,二者在对酸碱度的耐受能力、寄主植物偏好等方面也表现出不同的适应策略。
研究指出,灰霉菌约80年的演化反映了人类农业活动对微观生态系统的长期影响。通过比较老菌株与现代菌株,研究人员能够量化人为干预带来的生物学代价,有助于改善植物病害管理、生物多样性保护和推进可持续农业实践。
相关研究成果已发表在国际研究期刊《交叉学科》上。
【责任编辑:赵阳】目录 返回
首页
